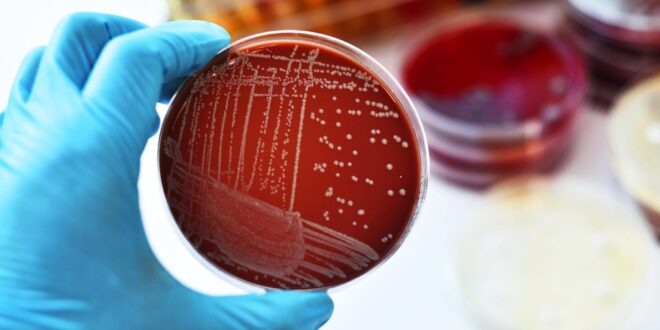

As Secretaria Municipais de Educação e Saúde de Santo Antônio de Pádua confirmaram nesta quarta-feira (08) a ocorrência de um caso de meningite bacteriana na rede municipal de ensino. O laudo laboratorial e o parecer técnico indicaram que o agente causador é a bactéria Streptococcus pneumoniae.
As autoridades de saúde emitiram uma nota para tranquilizar a comunidade, ressaltando que não há risco de contágio generalizado no ambiente escolar. Segundo o comunicado, o tipo de bactéria identificada não é transmitida por via respiratória, o que elimina a necessidade de suspensão imediata das aulas, de quimioprofilaxia coletiva ou de uma higienização especial do local.
Apesar da baixa transmissibilidade do agente neste caso específico, as Secretarias reforçam a importância de medidas preventivas básicas para toda a comunidade. As recomendações incluem manter os ambientes bem ventilados e arejados, reforçar hábitos de higiene como a lavagem frequente das mãos, e evitar o compartilhamento de objetos pessoais.
Um ponto crucial destacado na nota é o apelo para que pais e responsáveis revisem as cadernetas de vacinação de crianças e adolescentes. A rede pública de saúde oferece gratuitamente as vacinas que protegem contra as formas mais graves de meningite.
Por fim, o comunicado alerta a população para que procure imediatamente a unidade de saúde mais próxima em caso de aparecimento de sintomas característicos da doença, como febre, dor de cabeça intensa, rigidez na nuca, vômitos, confusão mental ou manchas vermelhas na pele. As Secretarias garantem que todas as ações estão sendo acompanhadas pelos órgãos competentes e seguem rigorosamente as diretrizes da Secretaria de Estado de Saúde do Rio de Janeiro.
Da redação da Rádio Natividade
 Natividade FM
Natividade FM